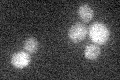
YIL147C
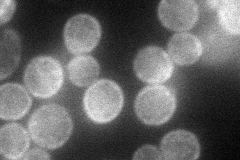
YIL147C
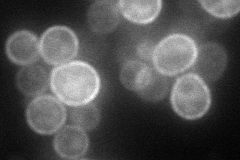
YIL147C
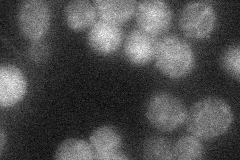
YIL147C
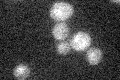
YIL147C

View description
Histidine kinase osmosensor that regulates a MAP kinase cascade; transmembrane protein with an intracellular kinase domain that signals to Ypd1p and Ssk1p, thereby forming a phosphorelay system similar to bacterial two-component regulators
Localization:
Intensity:
Fold change:
Significance:
-
C’ GFP library in SD
below threshold19.92 -
N' NOP1pr-GFP in SD
cell periphery54.3505 -
N' TEF2pr-mCherry in SD
cell periphery70.8327 -
N' NATIVEpr-GFP in SD
below threshold18.5825 -
N' TEF2pr-VC and Cyto-VN in SD

below threshold28.2578 -
C’ GFP library in SD+DTT

cytosol19.740.99No -
C’ GFP library in SD+H2O2

cytosol19.650.98No -
C’ GFP library in Starvation Media
cytosol19.310.96No -
C’ GFP library on the background of Pup2-DaMP

below threshold -
C’ GFP library on the background of CCT mutant

below threshold16.5670.831176No
